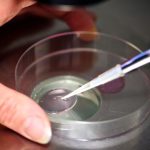
IVF research, FDA vouchers, dementia: Morning Rounds IVF research, FDA vouchers, dementia: Morning Rounds

The Southern Hoiho have asserted their dominance over the Mainland Pouakai with a convincing 102-66 victory in Dunedin.
This victory marks a significant turnaround for the Hoiho, who had suffered a 121-83 defeat to the Pouakai in their previous encounter.
The entire team contributed to the win, with five players reaching double figures in scoring.
Standout performances included Jessie Edwards with 19 points, nine rebounds, five assists, and two blocks, Claire Jacobs with 19 points, four rebounds, and four assists, and Taylah Simmons with 15 points, six rebounds, and four assists.
Defensively, the Hoiho were exceptional, limiting the Pouakai’s scoring options and showcasing their strength as a cohesive unit.
Overall, it was a dominant display from the Hoiho, who outplayed their rivals in all facets of the game.
Final Scores:
Southern Hoiho 102 (Jessie Edwards 19, Claire Jacobs 19)
Mainland Pouakai 66 (Esra McGoldrick 16, Morgan Yaeger 10)
Quarter scores: Hoiho 24-15, 51-32, 79-45.